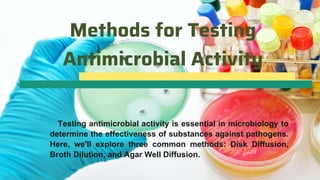
Methods for Testing
Antimicrobial Activity
Testing antimicrobial activity is essential in microbiology to
determine the effectiveness of substances against pathogens.
Here, we'll explore three common methods: Disk Diffusion,
Broth Dilution, and Agar Well Diffusion.

The proposed booklet serves as a comprehensive guide for studying the antimicrobial potential of plants, aimed at researchers and students. It covers topics such as collection, preparation of plant samples, extraction methods, and testing antimicrobial activity, emphasizing the importance of discovering new antimicrobial agents amid rising antibiotic resistance. The booklet also provides practical methodologies and ethical considerations for conducting research on the antimicrobial properties of various plant species.